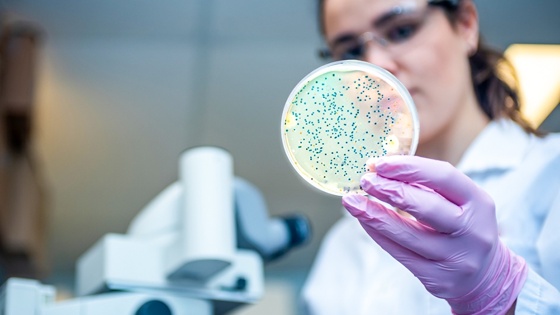

"Иммунитет и интеллект": врачи рассказали, зачем нужно заботиться о микробиоме
Сообщество микроорганизмов, существующих в нашем теле (на коже, слизистых, в кишечнике и т.д.) - микробиом - играет огромную роль в поддержании нашего здоровья. Он обеспечивает нормальную работу пищеварительной системы, участвует в обмене веществ, всасывании витаминов и микроэлементов, непосредственно влияет на иммунитет.
А научные данные последних лет закрепляют за микробиомом еще больше полезных функций: он и за эмоции отвечает, и даже за интеллект. На организованной ФИЦ питания и биотехнологии научной конференции "Кишечный микробиом: профилактика нарушений и пути коррекции" ведущие специалисты страны рассказали о недавних открытиях и обсудили практические подходы к улучшению микробиома среднего человека и влиянию этих изменений на его здоровье.
Одним из первых ученых, обративших внимание на роль микроорганизмов, обитающих в нашем кишечнике, был российский и советский физиолог, иммунолог и микробиолог Илья Мечников. В частности, ему мы обязаны тем, что на нашем столе есть такой замечательный кисломолочный продукт, как мечниковская простокваша (молоко заквашивается с помощью особых культур микроорганизмов, скрупулезно отобранных великим ученым). Мечников, кстати, считал, что поддерживая нормальную микрофлору кишечника мы не только улучшаем пищеварение, но и продлеваем себе годы здоровой жизни.
Сегодня ученые говорят: микробиом непосредственно влияет не только на пищеварение, но и работу буквально всех органов и систем - обеспечивает нормальный обмен веществ, помогает синтезировать и усваивать аминокислоты, витамины и микроэлементы, поддерживает работу печени, сердца и сосудов, иммунной системы, влияет на психику и эмоции и даже на интеллект.
Напротив, нарушение микробиома (дисбиоз) провоцирует массу неприятностей: гипогликемию, гормональные сбои, приводит к развитию метаболического синдрома, то есть выступает триггером ожирения, увеличивает риск дислипедемии и атеросклероза.
Как формируется микробиом
"Микробиом начинает формироваться еще до рождения в утробе матери, при заглатывании будущим ребенком околоплодных вод, затем нужные микроорганизмы попадают в организм новорожденного при прохождении родовых путей, вместе с молозивом и грудным молоком, позже - из внешней среды, вместе с пищей. Материнское молоко - одно из важных условий формирования здорового микробиома у ребенка, но не меньшую роль играет и питание, и среда, в которой растет ребенок, даже, например, наличие в семье питомцев", — рассказал детский врач-инфекционист, заместитель директора по научной работе ЦНИИ эпидемиологии, академик РАН Александр Горелов.
Сейчас в России распространенность грудного вскармливания не превышает уровня в 40%, то есть у шести младенцев из 10 микрофлора формируется на молочных смесях, чей состав хотя и стараются приблизить к материнскому молоку. Но это все равно искусственный продукт.
"Грудное молоко содержит около 200 олигосахаридов, обеспечивающих высокое биоразнообразие микрофлоры в будущем. Работая над рецептурой детских смесей, ученые создали биотехнологические аналоги олигасахаридов грудного молока, однако воссоздать смогли лишь пять из них", - рассказала заведующая лабораторией биобезопасности и анализа нутримикробиома ФГБУН "ФИЦ питания и биотехнологии" Светлана Шевелева.
По выражению Горелова, "микробиом надо беречь смолоду", и это не только отдавать предпочтение грудному вскармливанию. Содружество микроорганизмов в нашем кишечнике складывается постепенно, некоторые бактерии появляются только на пятом году жизни человека, а завершается этот процесс по мере взросления примерно к 20 годам, когда завершается формирование желудочно-кишечного тракта. При этом у каждого человека микробиом строго индивидуален.
"Кишечная микробиота руководит работой различных органов и систем, в том числе играет ключевую роль в становлении иммунитета. Замедление ее становления замедляет физическое и нервно-психическое развитие ребенка - такие дети позже поднимают голову, садятся, начинают с запозданием ползать и ходить", - рассказывает эксперт.
Как мы "портим" микробиоту
Самый главный неблагоприятный фактор - агрессивное воздействие антибиотиков. И это не только неоправданный прием антибактериальных препаратов, например, при так часто встречающихся у детей острых вирусных респираторных инфекциях.
"К сожалению, в животноводстве в нашей стране ежегодно используют 130 млн тонн антибиотиков. От 7 до 10% продукции разных производителей содержат остаточное количество антибиотиков, и мы это едим, в том числе дети. Это приводит к дисбиотическим нарушениям; дети чаще болеют ОРВИ, у них чаще развиваются аллергия, ожирение", - отметил Александр Горелов.
В пандемию положение еще более усугубилось: употребление антибиотиков выросло, их назначали врачи, а пациенты принимали самостоятельно "на всякий случай".
"Микробиота "помнит" каждый антибиотик 2-4 года, столько времени нужно на ее восстановление. Именно поэтому столь остро стоит сейчас проблема антибиотикорезистентности. И появление штаммов бактерий, устойчивых к известным лекарствам, - это только одно следствие бесконтрольного приема антибиотиков. Не менее важно и общее ухудшение здоровья населения из-за дисбиоза", - продолжает академик Горелов.
По его словам, сейчас огромное внимание уделяется разработке препаратов, помогающих восстановить микробиом.
Массовое производство продуктов питания, пищевые технологии влияют на качество продуктов, а через них и на микробиом, и это влияние может быть как положительным, так и отрицательным, рассказала Светлана Шевелева.
Самые простые примеры: тепловая обработка пищи защищает от наличия в ней патогенных микроорганизмов. Ферментация овощей, молока, злаков, с одной стороны, также уменьшает долю патогенов, а с другой - обогащает конечный продукт полезными для микробиома бактериями.
При этом массовое производство продуктов питание, широкое применение консервантов, массовые технологии, рафинирование, однозначно ухудшают продукты с точки зрения поддержания здорового микробиома.
Как "кормить" микрофлору
Сегодня уже доказано: регулируя свое питание, мы можем активно влиять на микробиом. Так, при однообразном питании в организме накапливаются определенные микроорганизмы, которые питаются компонентами тех продуктов, которые превалируют в нашем рационе. А разнообразие микробиома уменьшается.
Выход есть: питаться не просто разнообразно, но и следить за тем, чтобы в нашем рационе содержалась "еда" для полезной микрофлоры. Для этого ученые создают специализированные продукты, обогащенные полезными компонентами: пребиотиками, полифенольными соединениями, пищевыми волокнами. Второй путь более прямой - принимать пробиотики - препараты, которые содержать различные культуры полезных микроорганизмов. Но если их не "кормить", прием пробиотиков будет малоэффективен.
Как рассказала Светлана Шевелева, Всемирная диетологическая ассоциация провела исследование эффективности приема пробиотиков у взрослых и детей. У взрослых они помогали справиться с антибиотико-ассоциированной диареей после курса лечения антибиотиками, а также подавляли развитие бактерии хеликобактер пилори (этот патоген способствует развитию гастрита, язвы желудка и, как следствие, увеличивает риск рака желудка). Эффективным оказалось и применение пробиотиков у детей - от уменьшения нарушений пищеварения в первые месяцы жизни (колики, вздутие и т.д.) и до снижения рисков энтероколита.
Пребиотики - это компоненты еды, которые обеспечивают функционирование и размножение полезной микрофлоры. Это прежде всего пищевые волокна. В рафинированных продуктах их нет совсем. Богаты же ими цельные злаки, бобовые, овощи, фрукты, зелень, отруби.
"Организму необходимо постоянное поступление адекватного количества пищевых волокон, которых у нашего населения сегодня катастрофический дефицит. По данным нашего института, потребление пищевых волокон колеблется от семи до 21 грамма, между тем необходимая норма - 25 граммов. А вот в провианте российских солдат в начале века было 187 граммов пищевых волокон в сутки. Поэтому нам необходимо создавать специализированные пищевые продукты на основе пищевых волокон и олигосахаридов, обогащать кисломолочные продукты пробиотиками", - заключила Светлана Шевелева.